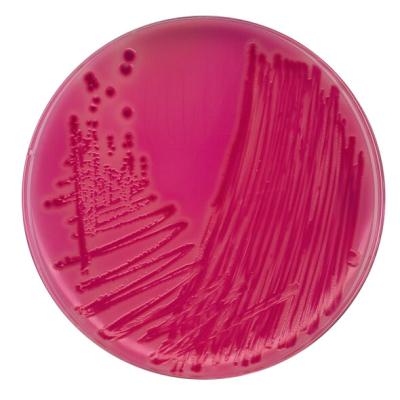
РАМБАХ-агар для идентификации сальмонелл 1075000001

РАМБАХ-агар для идентификации сальмонелл
Артикул:
1075000001
RAMBACH® agar for the identification of Salmonella
Подробнее
Запросить стоимость
Описание
Дифференциально-диагностическая питательная среда для идентификации сальмонелл, кроме Salmonella typhi, в пищевых продуктах и клинических образцахХарактеристики
|
Упаковка
|
4х250 мл |